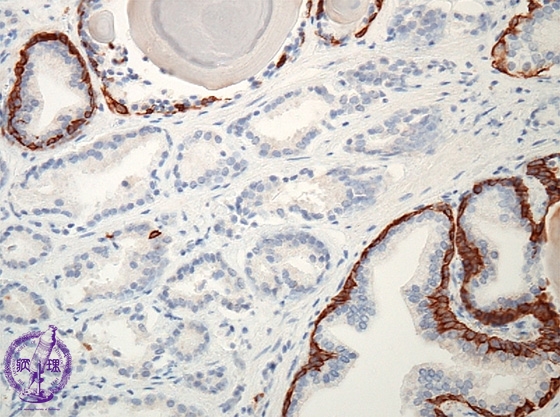

- 16.Male genital organs
- ★(2)Prostatic cancer (adenocarcinoma, Gleason grading system)
Histology (Immunohistochemistry, keratin 903): In non-neoplastic tubules (yellow dotted line), basal cells are immunohistochemically positive for keratin 903 (high molecular weight keratin). Therefore, this distinctive two layer structure is evident. However, adenocarcinoma (between blue dotted lines) forms without a two layer structure.
Click the image to see the enlarged image.